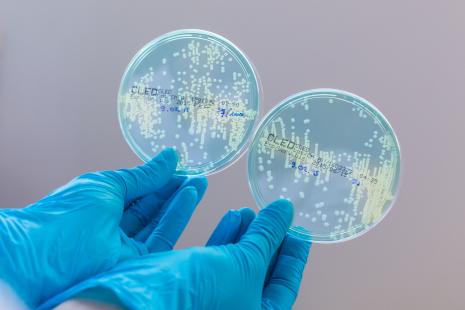
D’ici dix à trente ans, la biologie de synthèse pourrait permettre de créer des bactéries miroirs

Un colloque international en juin à l’Institut Pasteur à Paris, une réunion à Manchester cet automne, puis une autre à Singapour au printemps 2026 (1) : la fébrilité est réelle autour de la question de la vie miroir.
Jusqu’où autoriser les recherches sur la vie miroir ?
- 0 RéactionsCommenter
- Partager sur Facebook
Facebook
- Partager sur X
X
- Partager sur Linkedin
Linkedin
- Partager par mail
Mail
Alors que la création d’une cellule miroir est encore bien lointaine, la communauté scientifique s’organise dès aujourd’hui pour encadrer les travaux de recherche et inventer une gouvernance.
D’ici dix à trente ans, la biologie de synthèse pourrait permettre de créer des bactéries miroirs
Crédit photo : BURGER/PHANIE
La suite de l’article est réservée aux abonnés.
Inscrivez-vous GRATUITEMENT pour lire une sélection d’articles
Votre inscription nous permet de contrôler le contenu auquel nous avons le droit de vous donner accès en fonction de votre profession (directives de l’ANSM).
Je me connecte

« Parmi les livreurs blessés à vélo, deux tiers n’ont pas consulté, ni aux urgences ni en médecine de ville », alertent des chercheurs
Soignants en souffrance : la plateforme SPS relève une explosion des appels des étudiants en santé en 2025
One Health Summit : Macron appelle à plus de « coordination » internationale contre les pandémies
Banderole sexiste et bizutages à l'université de Tours : 16 étudiants sanctionnés